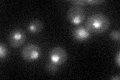
YIR023W
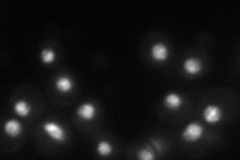
YIR023W
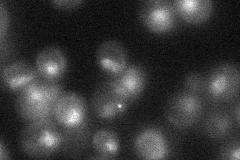
YIR023W
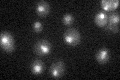
YIR023W

View description
Positive regulator of genes in multiple nitrogen degradation pathways; contains DNA binding domain but does not appear to bind the dodecanucleotide sequence present in the promoter region of many genes involved in allantoin catabolism
Localization:
Intensity:
Fold change:
Significance:
-
C’ GFP library in SD
nucleus23.16 -
N' NOP1pr-GFP in SD
punctate,nucleus44.6766 -
N' TEF2pr-mCherry in SD

nucleus57.7413 -
N' NATIVEpr-GFP in SD
punctate,nucleus20.4791 -
N' TEF2pr-VC and Cyto-VN in SD

nucleus37.8205 -
C’ GFP library in SD+DTT

nucleus26.761.15No -
C’ GFP library in SD+H2O2

nucleus26.581.14No -
C’ GFP library in Starvation Media
nucleus26.451.14No -
C’ GFP library on the background of Pup2-DaMP

nucleus -
C’ GFP library on the background of CCT mutant

nucleus28.39381.2253No
